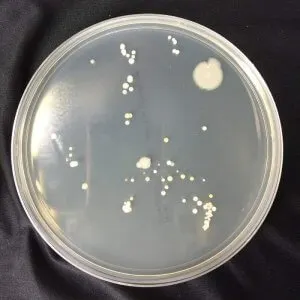
菌落，指的是細菌聚集起來所形成的聚落。雖然肉眼看起來只是一個小白點，但有可能就包含著成千上萬顆細菌。(Photo from 台美檢驗)

「生命的最小單位是什麼?」大家可能會不假思索的回答「細胞」,因為細胞是我們已知的最小生物,可以有意識地到處遊走,想去哪就去哪;反之,物質的話只能「水往低處流」似的、遵循著物理法則而變化。
但細思極恐的問題是:「既然細胞擁有自己的意識,那人類身體裡的細胞將近30兆個,那我們的意識究竟是從哪一顆細胞而來?還是我們就是『所有細胞的總和』?」作者是誰?
作者保羅·納斯於2020年獲得諾貝爾醫學獎,其貢獻是發現了控制細胞週期的基因序。細胞週期指的,是我們在國中生物課裡學過的「細胞分裂」。細胞分裂有一定的週期與速度,打從娘胎的時候,細胞會快速地成長、分裂,使孩子快速地長大成熟,之後則隨著年紀老邁而停滯。而保羅的發現,正是在告訴著世人:「嘿!這個細胞分裂是有『油門』的!」試想……倘若真的能夠讓老年人的細胞週期繼續"催下去",那麼是不是就有可能達到長生不老了呢?
英文書名《What is the life》是與物理學家薛丁格的著作《生命物理學講義》的英文書名相同,就是為了紀念這位開啟生物物理學研究的先驅。當年薛丁格並沒有電子顯微鏡,也沒有電腦、AI可以幫忙計算,所以他只能透過物理、化學的理論去揣摩生命的構成。而《生命之鑰》則是用現代的生物學研究,給《生命物理學講義》做了大量的補充。
雖然書中有很多有趣的新知想跟大家分享,但讀完卻很難將所有的知識點串在一起,所以只梳理了主軸的故事「怎麼發現細胞週期」跟大家分享。
延伸閱讀:從物理學出發,理解生命的秘密——薛丁格生命物理學講義讀後筆記
怎麼發現細胞週期的?
保羅一開始的研究方向只設定在「細胞分裂」的這個大方向,並針對酵母菌的生長週期進行觀察,因為酵母菌具有容易繁殖、染色體少(只有16條)的特點,比起其他動植物更合適作為實驗的對象,希望能中找出控制細胞分裂的特定基因。
保羅一開始的假設是:如果細胞週期的「油門壞了」,細胞分裂便無法正常啟動,那麼變異的酵母菌就無法將自己分裂出去,於是越長越大。而保羅的團隊也確實有找到那些巨大的酵母菌,但他們染色體的基因變異有多達500處,實在很難指出誰才是最關鍵的那個基因。
後來保羅靈機一動,便將目光轉向其他小到幾乎看不到的酵母菌菌落。「油門壞了」有時指的是「車發不動」,會不會有時候反而是指「暴衝」的現象呢?當酵母菌在還沒長大時卻「提早催油門」,就會導致他被強製分裂成一顆顆酵母菌寶寶;而下一代的酵母菌寶寶又會依循相同的基因訊息,進行未成年增殖,形成一群寶寶菌落。而這個寶寶菌落不僅超級難找,又因爲發展不完全,很容易受到環境的變化或其他細菌的入侵而團滅,光是要找到他們就使保羅的團隊們傷透腦筋了!
對這兩種油門壞掉的酵母菌進行測試後,保羅也成功將細胞週期的控制基因縮減到2~3個,並將最重要的那段基因命名為cdc2,實為重大的里程碑。雖然證明了「cdc2是控制酵母菌的細胞週期」,但這樣的結果只證明了酵母菌的特性,那人類或是其他生物,又是用什麼控制的呢?
光是研究酵母菌的實驗就歷經了15年,倘若又要研究其他更複雜的生物,那該要花多久啊?正當保羅的團隊在討論時,突然冒出一個怪誕的想法:
「可是,如果我們也跟酵母菌一樣、都是用同樣的cdc2控制細胞週期呢?」這樣不就能夠很快地偷吃步、完成實驗了嗎?
衝著這句話、研究團隊姑且一試,將人類健康的DNA參入這些cdc2不良的酵母菌當中,發現這些「不良少年」竟真的可以從人類DNA中,擷取自己遭破壞的那段基因,成功修復自己並長大成熟!這不僅證實了人類與酵母菌擁有共同的cdc2基因,保羅在書中更是寫下那段細思極恐的推論:
人類與酵母菌本質上就是完全不同的生物,但這兩個物種卻都是用cdc2這段基因序在控制著細胞分裂。會不會打從生命之初,細胞就是用cdc2來控制細胞分裂,即使過了數十億年的演化,這段基因序列仍舊透過生物的繁衍、繼續傳遞著。
「現今地球上的生命只啟動過一次」,所有的生物都遵照著DNA、RNA、蛋白質之間的維持生命、成長並繁殖。保羅發現的cdc2或許就是從遠古細胞一直傳承下來的其中一段基因,這個結論也不禁令人好奇地想:會不會還有其他億年不變的基因存在呢?
延伸閱讀:《自私的基因》閱讀心得|理解自私,才可能選擇不自私
「探究生命」究竟有什麼重要的?
「究竟怎麼樣算是生命?(What is Life?)」或許這種議題,在我們這些販夫走卒之間只是個閒聊的話題,但對於一些最尖端的科學家來說,卻有著舉足輕重的影響。
目前學界都公認:當人類的精卵結合時,這個胚胎就算是一個生命,所以不可以剝奪他的生存權。而受精卵所形成的第一個細胞,又被稱為「胚胎幹細胞」或「萬能幹細胞」,因為他幾乎可以形成任何一種組織或器官,就像是小孩子長出新的器官那樣。而聰明的科學家、商人也會將歪腦筋動到「胚胎幹細胞移植」的身上,倘若能夠把胚胎幹細胞賣給器官受損的人,那豈不是太有賺頭了?但正是因為「胚胎即生命」,所以所有想碰胚胎幹細胞的研究,都必須經過嚴密的審查才能進行。倘若一開始認為「要有心臟、有心跳才算是有生命的人類」,那麼這個社會可能將會以另一種方式在運作。
如今「CRISPR—分子剪刀」的技術問世,這把剪刀號稱可以從基因的維度來修改生物。近期最出名的案例便是「在實驗室裡成功地將細胞核裡、唐氏症的基因序剪除」。不難想像,未來可能只要孩子被診斷出唐氏症,就可以在胚胎的時候就可以被「治癒」。雖然是個令人振奮的消息,但我們也不敢保證,這剪刀不會拿去「剪」其他東西,例如智商、身高,或是外表?如果可以「剪」出一個完美、無病症、十項全能的孩子(幾乎可以算是「客製化」),那麼這樣的生命還算是生命嗎?倘若答案是否定的,那麼「客制化」到什麼程度,才算是合乎道德呢?
人類的好奇心與慾望推動著科學的發展,而最先進的科學也似乎正在刺探著我們對道德的底線。面對極端的道德題,或許我們的答案還沒有辦影響外在的世界,但卻可以幫助我們釐清自己的信念與價值觀;無論自己的想法是高尚或是醜陋,都是很好的思想練習,並帶領我們更深地認識自己。

──書籍資訊──
書名:生命之鑰: 諾貝爾獎得主親撰 一場對生命奧祕的美麗探索
作者:保羅‧納斯
譯者:邱佳皇
出版社:三采文化
出版日:2021/12
誠品線上書店連結